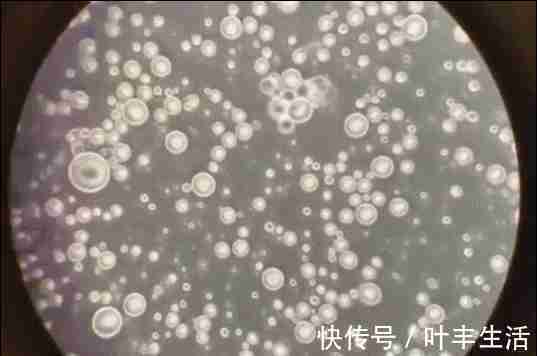
母乳喂养|为啥吃母乳的宝宝体格“倍儿棒”? 母乳具备的优点,奶粉难模仿

母乳喂养|为啥吃母乳的宝宝体格“倍儿棒”? 母乳具备的优点,奶粉难模仿
人人都说吃母乳好,却不知道具体好在哪里,省钱、方便或是安全都是老生常谈的好处。母乳喂养带来的好处远不止这些,对宝宝尤为重要。
二胎宝宝长得肉嘟嘟,“体格”却没有姐姐小时候强壮
小葳生头胎女儿时,夫妻俩的条件还有些差,怀孕时就担心宝宝出生后“没饭吃”怎么办。
好在那时小葳的母乳比较足,为了让女儿吃饱,她平时特别注意自己的饮食和生活习惯,生怕母乳因为自己不良习惯变少。

文章插图
后来她生下二胎女儿,由于是剖腹产再加上月子里有些生气,母乳量明显比生头胎时少了。
不过有二胎后,家里的条件变好了不少,母乳不足小葳也没担心,出月子就给宝宝买了一款很贵的奶粉。喂养期间连连感叹,小女儿喝奶粉长大比姐姐胖多了。
可渐渐地,小葳发现二胎比姐姐小时候更爱生病。小家伙看起来肉嘟嘟的,体格却不如姐姐小时候强壮。问了其他宝妈后,大家都表示这就是吃奶粉和母乳的区别。

文章插图
母乳喂养所具备的优点,再贵的奶粉也模仿不来
吃母乳长大的宝宝往往“体格倍儿棒”,这是因为母乳的优点独特,对宝宝非常有益,再贵的奶粉也无法模仿和复制。
▼ 吃母乳的宝宝可获得更多免疫力
宝宝的体质咋样受免疫力影响很大,而这种免疫力是奶粉添加再多营养成分也无法给予宝宝的。
大家看到奶粉的配料表上有密密麻麻的营养添加,以为这些营养足够宝宝成长了,母乳看上去很清淡未必有奶粉好。实际上母乳有自己营养配比,营养成分种类丰富远远超过奶粉。
【 母乳喂养|为啥吃母乳的宝宝体格“倍儿棒”? 母乳具备的优点,奶粉难模仿】

文章插图
母乳中单是能检测出对宝宝身体有益的菌类将近700种,而且许多营养成分是无法人为添加到奶粉中的。
或许吃母乳的宝宝看上去比奶粉喂养的宝宝瘦一些,但都是“结实肉”,体质并不会太差。
▼ 吃母乳的宝宝肚肚通常很舒服
尽管奶粉的工艺一再改进,强调小分子利于宝宝吸收,在好消化这一点上还是输给了母乳。

文章插图
吃母乳的宝宝很少会出现过敏的情况,因为很好消化和吸收,宝宝一般会攒肚很少发生便秘。小婴儿肠胃不舒服容易哭闹,吃母乳的宝宝肚肚舒适哭闹也少了很多。
▼ 母乳“新鲜”又纯净,用显微镜放大后很震撼
将母乳挤到瓶子里和奶粉做对比,外观看上去或许只是颜色的差异,但各取一滴放在显微镜下观察可看出巨大差别。
首先母乳放大后很纯净,只有营养成分完全没有杂质,在显微镜下是微微蠕动的,也就是说母乳是“活的”,可想而知对宝宝身体有多大的好处。
文章插图
奶粉从牛奶(羊奶)挤出来再到加工、灌装和储存,从时间上对比不如宝宝随吃随有的母乳新鲜,这是奶粉无法复制的优点。
通过母乳喂养换来的亲子时光,奶粉永远做不到
选择母乳喂养的宝妈,其实并不会反复研究母乳具体有哪些好处,省钱方便也不是她们坚持下来的动力。
- 都说第一个出生的娃更聪明,那为啥有“老二聪明老大呆”的说法?
- 妈妈们|劝告母乳喂养宝宝时有6个表现,要停止喂养,再喂就该积食了
- 小蝌蚪|同样是50岁,为啥有些人还能生,有些人却不行?夫妻俩谁的问题?
- 同样是50岁,为啥有些人还能生,有些人却不行?夫妻俩谁的问题?
- 过去东躲西藏,现在一催再催,三胎为啥“遇冷”?年轻人说出心声
- 水果|宝宝肠胃弱,但很多人还不知道原来这几种喂养方式竟然是错误的
- 晚生|为啥有的宝宝37周就出生,有的却要等到40周?早生晚生有什么区别
- 同一罐奶粉,为啥超市卖180,网上却卖80?奶粉厂离职员工揭
- 哺乳期,宝妈尽量注意3件事,或许母乳更健康,别不放在心上
- 育儿干货:掌握猛涨期3个信号,喂养要跟上,助力娃“生长开挂”